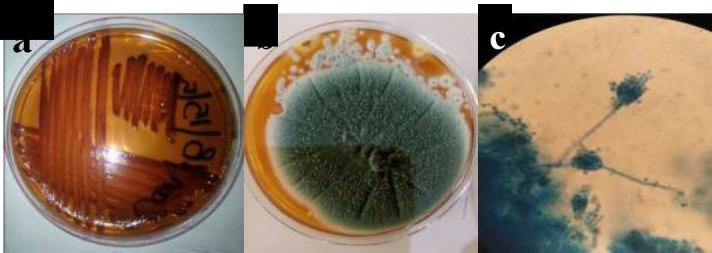
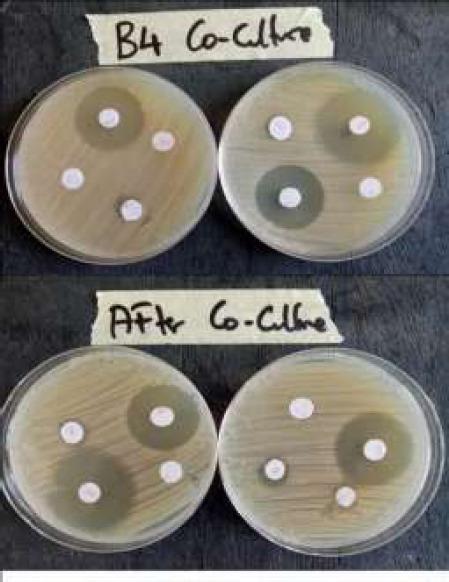

物种对……抗生素耐药性特征的影响
EFFECT OF SPECIES ON THE ANTIBIOTIC RESISTANCE PROFILE OF .
作者信息
Samia Alkhalil S
机构信息
Department of Clinical Laboratory Sciences, College of Applied Medical Sciences, Shaqra University, Alquwayiyah, Riyadh, Saudi Arabia.
出版信息
Afr J Infect Dis. 2024 Mar 8;18(2):8-18. doi: 10.21010/Ajidv18i2.2. eCollection 2024.
BACKGROUND
Infectious diseases due to antibiotic resistant pathogens are a global public health problem. This study aimed at determining the potential effect of bacterial-fungal interaction on the antibiotic susceptibility profile of
MATERIALS AND METHODS
was isolated from water samples. The isolate was identified using the conventional biochemical tests and the 16S rRNA molecular sequencing technique. Additionally, species was isolated and identified based on colony morphological characteristics and microscopic features. Standardized isolates were co-cultured in broth medium. Antibiotic susceptibility evaluation of the from the co-culture and the original was carried out using the Kirby bauer disk diffusion method.
RESULTS
The antibiotic susceptibility profile of before and after co-culture remained largely unchanged except in the case of chloramphenicol, where the isolate showed reduced susceptibility. Molecular analysis of resistance gene revealed the absence of tested gene encoding antibiotic resistance, including the streptomycin resistance (str) genes ( and ) and the erythromycin resistance methylase () gene.
CONCLUSION
The result of this study showed that there is a minimal influence of cultures on the susceptibility of . Further research involving a wide spectrum of microorganisms and their interactions should be conducted to acquire a thorough understanding of the influence of microbial interactions on antibiotic susceptibility profiles in order to pave way for novel strategies to combat antimicrobial resistance.
背景
由抗生素耐药病原体引起的传染病是一个全球公共卫生问题。本研究旨在确定细菌 - 真菌相互作用对[未提及具体微生物名称]抗生素敏感性谱的潜在影响。
材料与方法
[未提及具体微生物名称]从水样中分离得到。采用传统生化试验和16S rRNA分子测序技术对分离株进行鉴定。此外,[未提及具体真菌名称]根据菌落形态特征和微观特征进行分离和鉴定。将标准化的分离株在肉汤培养基中共同培养。采用 Kirby - bauer 纸片扩散法对共同培养后的[未提及具体微生物名称]和原始[未提及具体微生物名称]进行抗生素敏感性评估。
结果
除氯霉素外,共同培养前后[未提及具体微生物名称]的抗生素敏感性谱基本保持不变,在氯霉素的情况下,分离株显示敏感性降低。耐药基因的分子分析显示不存在所检测的编码抗生素耐药性的基因,包括链霉素抗性(str)基因([未提及具体基因名称]和[未提及具体基因名称])和红霉素抗性甲基化酶([未提及具体基因名称])基因。
结论
本研究结果表明[未提及具体微生物名称]培养对[未提及具体微生物名称]敏感性的影响极小。应开展涉及广泛微生物及其相互作用的进一步研究,以全面了解微生物相互作用对抗生素敏感性谱的影响,从而为对抗抗菌药物耐药性的新策略铺平道路。